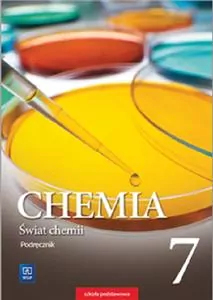
Świat chemii. Chemia. Podręcznik. Szkoła podstawowa Klasa 7 - tantis.pl
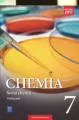
Świat chemii. Chemia. Podręcznik. Szkoła podstawowa Klasa 7 - tantis.pl
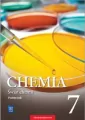
Świat chemii. Chemia. Podręcznik. Szkoła podstawowa Klasa 7 - tantis.pl

Świat chemii. Chemia. Podręcznik. Szkoła podstawowa Klasa 7
Podręcznik Świat chemii to chemia bez zawiłości ponieważ: Język przekazu dostosowany do wieku i poziomu umiejętności uczniów ułatwia zrozumienie chemii. Treść przedzielono śródtytułami w formie pytań, aby wykład budził zaciekawienie. Odpowiedzi na pytania uczeń znajdzie w krótkich blokach tekstu. Taka forma, znana młodzieży z internetu, pozwala na zapoznawanie się z materiałem w odpowiedniCzytaj więcej
- Numer dopuszczenia: 834/1/2017
- Wydawnictwo: WSiP
- Serie: Świat chemii, Chemia WSiP
- Data premiery: 2017-08-09
- Okładka: miękka
- Liczba stron: 208
- Wymiary: 240 x 170
więcej parametrów
O książce
Dane szczegółowe
Numer dopuszczenia
834/1/2017
Identyfikator produktu
727787
Tytuł
Świat chemii. Chemia. Podręcznik. Szkoła podstawowa Klasa 7
Producent
Serie:
Klasa
7
Typ publikacji
tradycyjny podręcznik
Wydanie
1
Język
polski
Język oryginału
polski
Liczba stron
208
Typ okładki
miękka
Data premiery
2017-08-09
Rok wydania
2017
Wymiary
240 x 170
Waga
0.38 kg
Wysokość
8 mm
Długość
242 mm
Głębokość
170 mm
Liczba elementów zakres
Do 49
Szerokość
170 mm
Nasza cena
48,40 zł
Bądź pierwszy!
Twoja recenzja produktu “Świat chemii. Chemia. Podręcznik. Szkoła podstawowa Klasa 7” będzie bardzo przydatna dla innych użytkowników.
Recenzje produktów są zarządzane przez stronę trzecią w celu weryfikacji autentyczności i zgodności z naszymi wytycznymi dotyczącymi ocen i recenzji
Recenzje
Każdą z recenzji weryfikujemy na trzy sposoby:
- Klient zweryfikowanyAutorzy recenzji z tym oznaczeniem są naszymi klientami. Kupili ten produkt w sklepie tantis.pl.
- Klient niezweryfikowanyAutorzy recenzji z tym oznaczeniem są naszymi użytkownikami, ale nie możemy potwierdzić, że kupili ten produkt w sklepie tantis.pl.
- Recenzja ZweryfikowanaPotwierdzamy, że prezentowana opinia może dotyczyć danego produktu i zawiera elementy jego recenzji.
Dostawa i płatność











